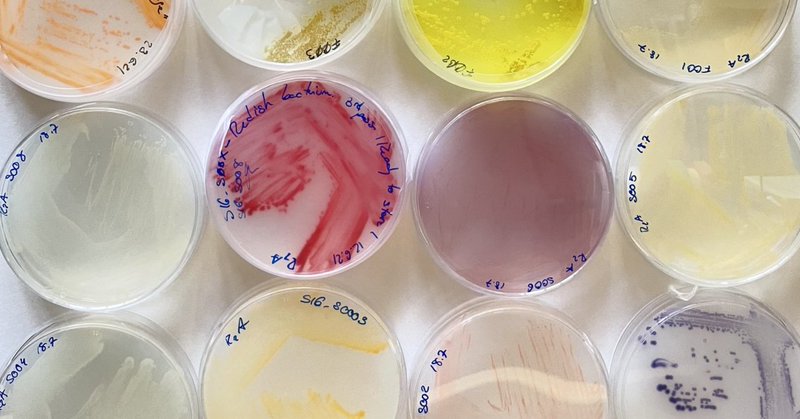
Tweet card summary image

Lea Fuchs
@FuchsiLea
Followers
47
Following
259
Media
3
Statuses
39
PhD, microbiologist working in medical device industry
Joined April 2020
I'm happy and proud to announce that this week I successfully defended my phD thesis. This journey has been incredible and I thank everyone who supported me in this chapter of my life. I now look forward with great joy to the next steps of my career and the adventures to come.
3
0
28
Very excited this work is now out🥳 A big thank you to our colleagues at the Vorholt Lab for the excellent collaboration made possible through the @NCCRMicrobiomes! Congratulations to all the authors! More at
science.org
Interactions between plant-associated bacteria are recapitulated by experimentally informed genome-scale metabolic models.
Very excited our latest work is now available at @ScienceMagazine Many congratulations to all the authors and a big thank you to our colleagues at the Vorholt Lab for the excellent collaboration, enabled through the @NCCRMicrobiomes More:
0
1
19
Tell me what you eat, and I will tell you how you compete. A new study by the Vorholt Lab @Microbio_ETH @ETH_en with @realLCSB at EPFL predicts bacterial interactions with high accuracy using metabolic modelling. More: https://t.co/B1lsx180G0
0
21
74
Our gut: a bacterial hotspot for plasmid transfer! But how can related bacteria coexist if they compete for resources? ETH researchers found that even a single difference in carbon usage can be enough. More: https://t.co/dbT06wQvNg 🌱#Microbiology #BacterialCoexistence
0
1
1
Fueling Salmonella:Hardt lab @Microbio_ETH reveal ability to utilize single-carbon source (galactitol/arabinose) enables #Salmonella to bloom in gut pre-colonized by another Enterobacteriaceae. This also promotes transfer of #antibiotic resistance plasmids https://t.co/lZKe8BTWEM
0
9
28
📣Open position @NCCRMicrobiomes! The @SunagawaLab is seeking a web and database developer to contribute to the development of a global-scale database of genomic information derived from environmental microbiomes. More info here:
nccr-microbiomes.ch
0
14
16
Strain-specific utilization of distinct carbon sources determines co-existence and plasmid transfer between Salmonella strains in the mouse gut: a new @NCCRMicrobiomes publication. Congrats to all authors! @Microbio_ETH
0
3
8
#PhDposition in "Microbial population dynamics within the Arabidopsis leaf microbiota" available in the #VorholtLab! More info here 👉 https://t.co/2LXXS4oyKN
0
10
9
A lot of great labs throughout Germany are currently recruiting new PhDs within CRC 1371 Microbiome Signatures! Spread the word 🌞
sfb.tum.de
0
1
4
Are you interested in doing an internship or a short-term research stay in one of the @NCCRMicrobiomes labs? Check out our new fellowship programme! Undergraduates, PhD students and postdocs are eligible for stays of up to 12 months. Find out more here:
3
46
91
We have 2 open #postdocposition ! Help us explore the interactions between drugs and the gut #microbiome, including their effects on the host, and join our collaborative & diverse group in an exciting research environment @uni_tue ! Please apply here: 👇 https://t.co/jFgCQNiuyx
3
74
79
Today the yearly "MINT" week of Gymnasium Rämibühl visited ETH Zurich again! Thanks to Julia Vorholt, Wolf Hardt and guides for presenting the biology curriculum and a current research topic and showing them various research projects in the IMB laboratories.
0
1
19
I was happy to contribute to this interesting work by Leanid Laganenka! Congrats Leo to this great publication!
OUT NOW: Chemotaxis and autoinducer-2 signalling mediate colonization and contribute to co-existence of Escherichia coli strains in the murine gut by Wolf-Dietrich Hardt & co @Microbio_ETH
0
1
11
Last week I enjoyed beeing back in science after having this little one! Great talks, posters and interesting people! #NMetC2022
1
1
29
Just arrived at the ceremony hall copenhagen at #NMetC2022! If you are interested to learn more about #Salmonella and their metabolism come and see my poster on thursday!
0
1
15
Interested in joining the Life Science Zurich Graduate School (LSZGS) as a PhD student? The next application deadline is 1st July 2022 LSZGS is the home of 19 PhD Programs including us @MimZurich! https://t.co/JfQQYjAwmJ
lifescience-graduateschool.uzh.ch
0
4
5
Open position for a bioinformatician/computational biologist based at @Microbio_ETH for collaborative work on exciting @NCCRMicrobiomes projects. Thanks for spreading! https://t.co/FjLUYgCmcE
0
21
22
We looked at how horizontal gene transfer might influence the emergence and stability of cooperative virulence in Salmonella. Just out @NatureComms with @DiardLab. https://t.co/CtRGj5LaDF . More details below!
nature.com
Nature Communications - Salmonella Typhimurium virulence is costly and can be lost by mutation during infection. Bakkeren et al. show that virulence restoration via horizontal gene transfer is only...
3
30
105
#JobOpportunity in the Lab of Markus Künzler: PhD Position - Dissection of the molecular crosstalk between bacteria and fungi https://t.co/NsomIDhTBW
0
3
3